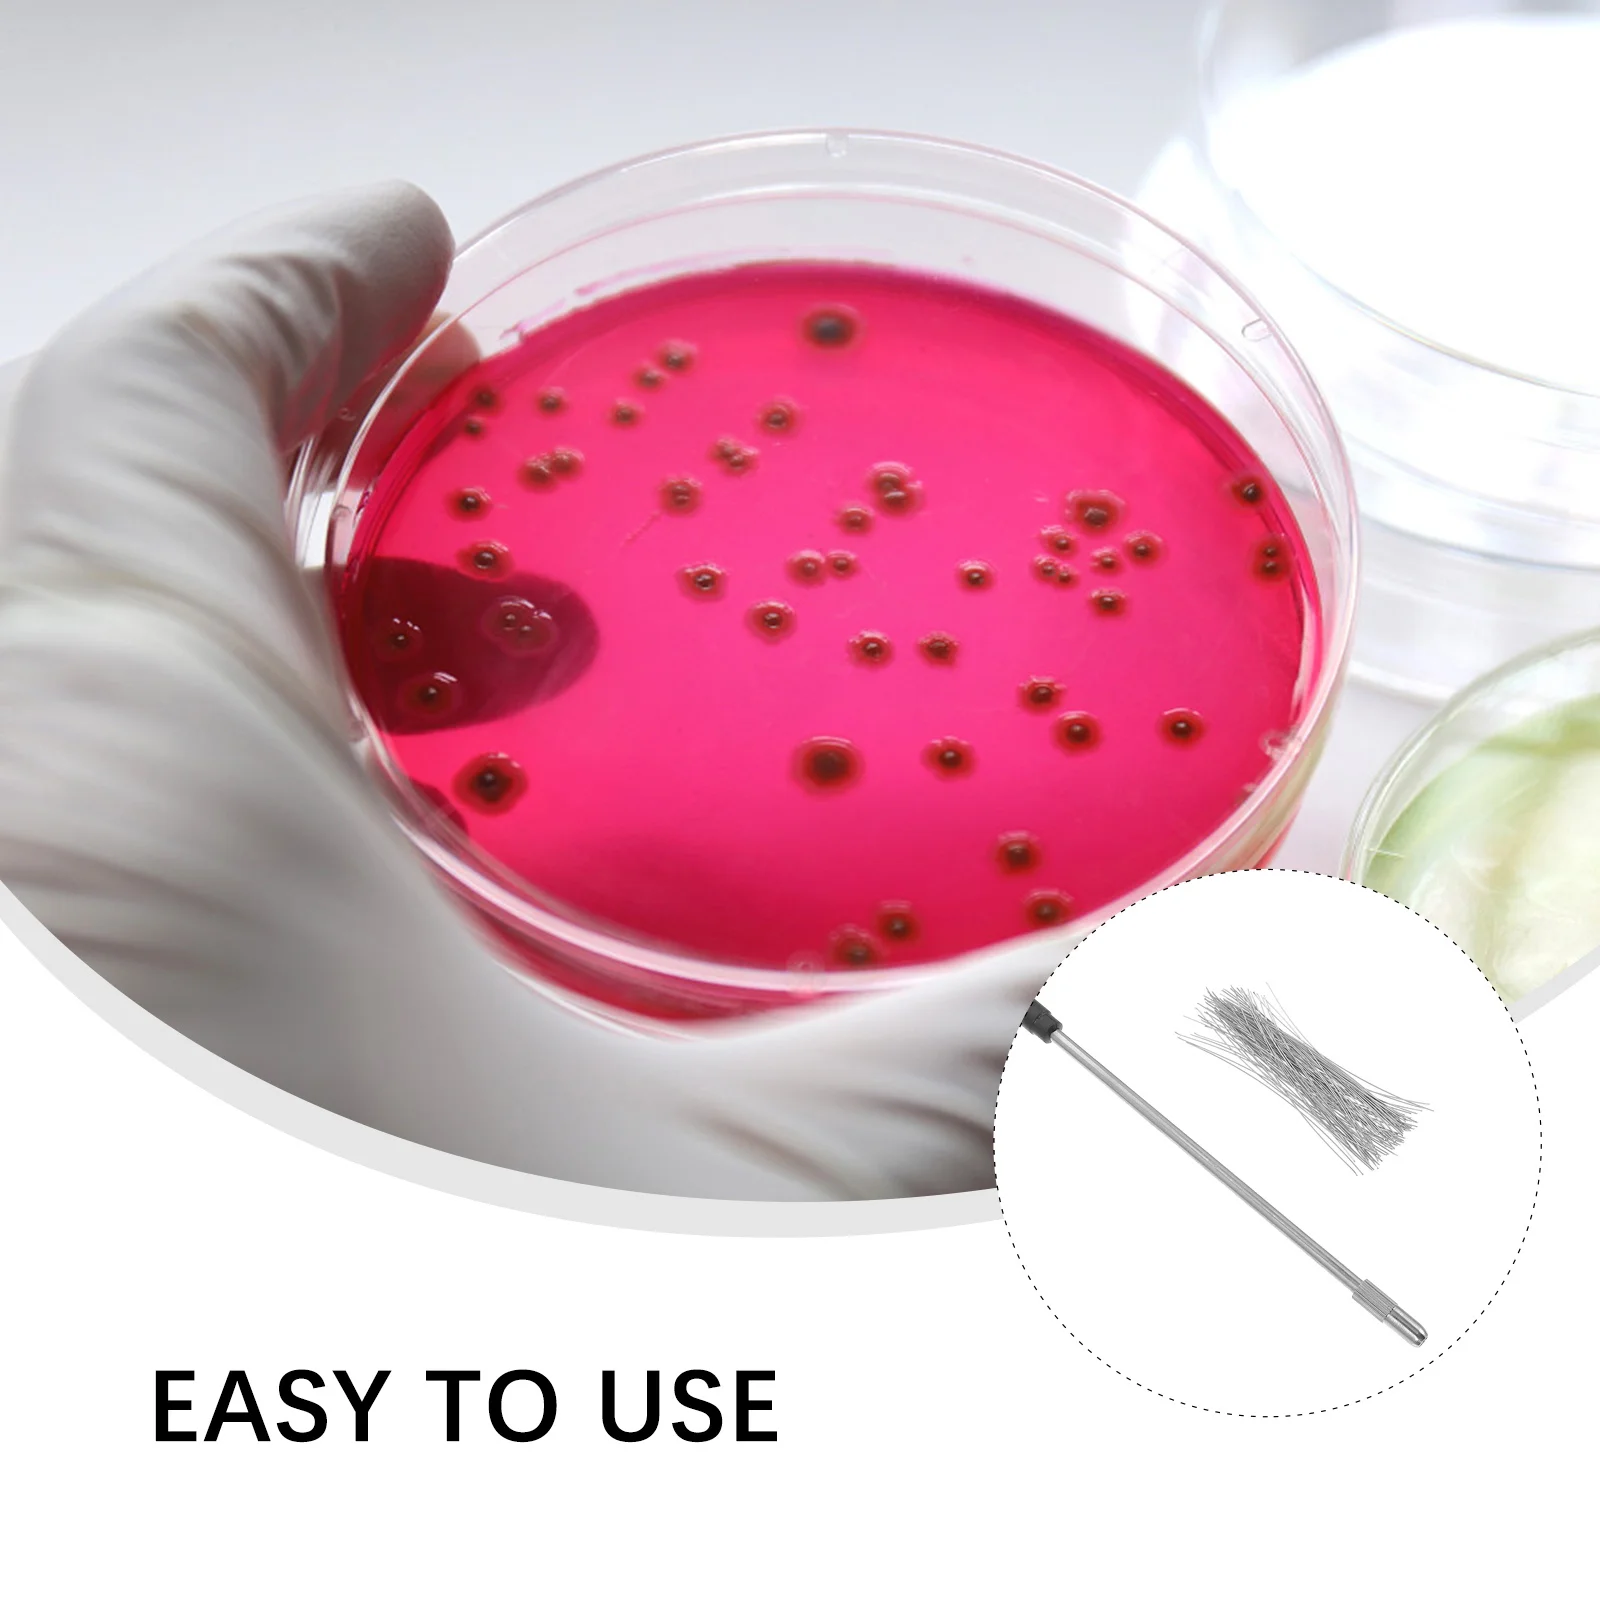
1 set 1 Set Stainless Steel Inoculating Loop Rod For Experiment Tool Microbiology Inoculation Wire Device Parts

Свитшот для женщин с аутизмом, винтажные худи с животными и стрекозой, Женская Повседневная модная одежда, цветной Женский свитшот с аутизмом
График изменения цены & курс обмена валют
Пользователи также просматривали

$43.27
10X электрический велосипед 5 светодиодных задних фонарей Электрический велосипедный фонарь для электронного велосипеда
aliexpress.ru
$193.00
14,0 дюймов для Dell Inspiron 14 5482 5485 5491 P93G P93G001 2-в-1 FHD 1920*1080 IPS дигитайзер в сборе + петли верхняя часть
aliexpress.ru
$14.11
Размера плюс сексуальный женский кожаный Облегающий комбинезон в стиле фетиш черный ПВХ боди с открытой промежностью порно плюшевое белье Эротический латексный костюм
aliexpress.ru
$116.35
messenger underarm bag shoulder shopping crossbody bags handbags genuine leather designer handbag purse sling pouch zipper women adjustable
dhgate.com
$224.38
zq Modern Minimalist Creative Bar Armchair Leisure Bar Stool High Stool Cafe Bar Chair
aliexpress.com
$546.00
Автомобильный радиоприемник на Android с экраном 12,3 дюйма для Audi A6 A6L A7 2012-2019, автомобильный аудиоприемник, GPS, мультимедийный DVD-плеер, правый руль
aliexpress.ru
$0.98
Best Friends Good Friend Compass Necklace Valentine's Day Gift Lovers Necklace Set
aliexpress.ru
$56.96
Дезодорирующий Power Ales Nursing Care Дезодорант Nursing Care Подгузник для мусора Освежающий цитрусовый 2 x 3 Подгузники для взрослых Товары для ухода за больными Дезодорант
joom.com
$8.97
Чехол DF для Infinix Smart 6 Plus с магнитом и кольцом Black inArmor-01, Infinix Smart 6 Plus
pleer.ru
$23.69
Cardigan Plus Size Sweater Sexy Black Hollow Sweater Coat Sweater For Women Outerwear Autumn Winter Warm Long Sleeve Jacket
aliexpress.com
$3.76
Bottle Spout Pourers Pourer Bar Spouts Steel Stainless Oilfree Flow Dispenser Syrup Coffeeset Home The Accessories Olive Pour
aliexpress.com
$3.66
Bubble Wedding Bottle Champagne Bubbles Bottles Favors Wandsanniversary Party Empty Mini 50Th Gifts Decoration Bulk Tubes Small
aliexpress.com
$11.99
Автомобильный беспроводной пылесос для очистки автомобилей, автомобильные товары, товары для автомобилей, бытовая техника для Infiniti FX FX35 FX37 ...
aliexpress.ru
$8.21
CARCTR Universal 12MM Mini Air Filters Mushroom Head for Car Motorcycle Cold Air Intake High Flow Vent Automobiles Filters
aliexpress.ru
$38.30
Disney Marvel Spiderman Neckband Wireless Bluetooth Headset Music Player Earbuds Video Call Portable Sports Headset
aliexpress.ru
$6.34
4/9pcs Universal Car Covers For LADA Vesta Renault K2 Kia Cover Rio Logan K3 VW Drop Shipping Protector Car
aliexpress.ru
$10.00
Оригинальный переходник для зарядного устройства для путешествий + кабель типа C для Leeco Cool 1 Dual letv Coolpad Cool1 5,5 "FHD Бесплатная доставка
aliexpress.ru
$62.15
vintage western rhinestones belt removable buckle cowboy cowgirl bling leather crystal studded belt for women men, Black;brown
dhgate.com
$23.16
women embroidery letters washed crop tee with hem short sleeve cotton crop t-shirt in blue, White
dhgate.com
$96.08
luxurious quality s925 silver punk bracelet grey shell and diamond for women charm party jewelry gift ps3446, Golden;silver
dhgate.com
$5.05
retro nine card mobile phone case for iphone xs max x 8 7 plus multi-card position lens protection wallet s9 s8 plus
dhgate.com
$2.27
Печать Шаблон Кошелек Кожаный Чехол Телефон Случае Для Samsung Galaxy A21 - Мопс, Galaxy A21
tvc-mall.com
$29.99
baby girls autumn ruffle shirt long sleeve infant girls blouse lotus collar kids girl outwear pink white yellow for 9-48m, White;black
dhgate.com
$29.21
стильный лето женщины платье vintage рукавов bodycon v-образным вырезом casual вечера партии твердая полиэстер мини платья комбинезоны # 541, Black;gray
dhgate.com
$7.63
1 set 1 Set Stainless Steel Inoculating Loop Rod For Experiment Tool Microbiology Inoculation Wire Device Parts
aliexpress.ru
$5.29
Piper Cub T-ShirtPiper Cub Aircraft Baseball Cap Luxury Brand Beach Bag fashionable tea Hat Baseball Men Women's
aliexpress.ru
$356.18
ZZ Children's Game Fence Protective Grating Baby Indoor Baby Crawling Mat Home Living Room Paradise Toddler
aliexpress.com













